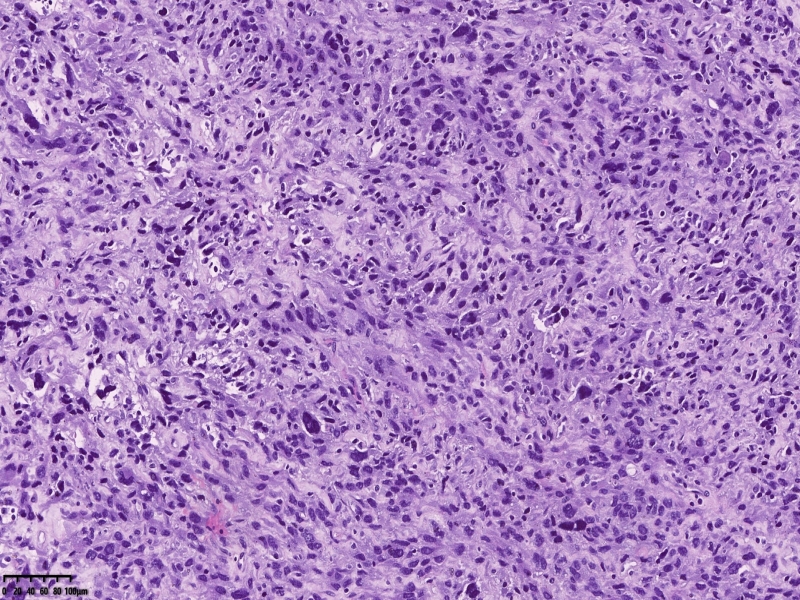
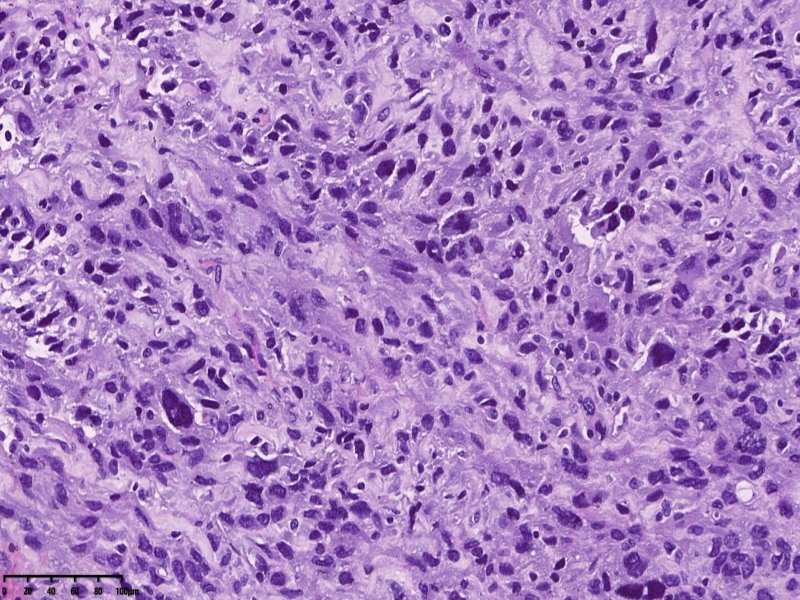
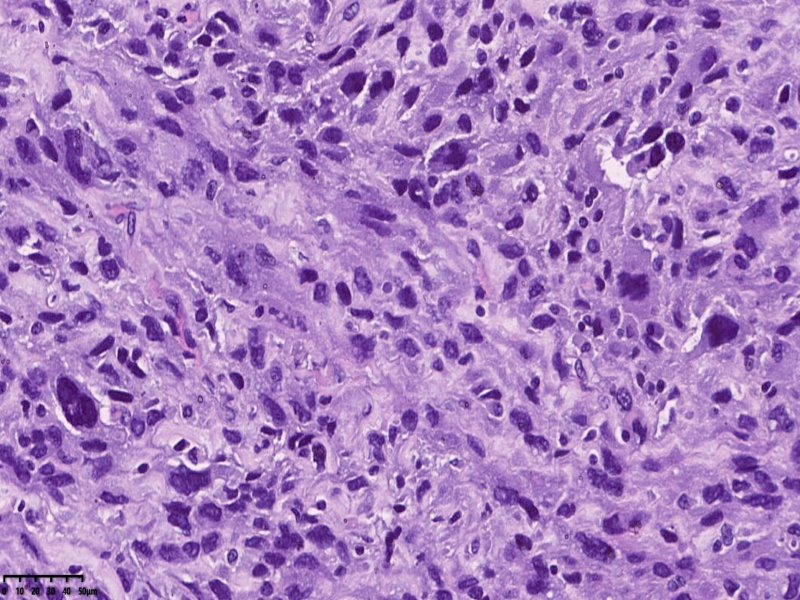
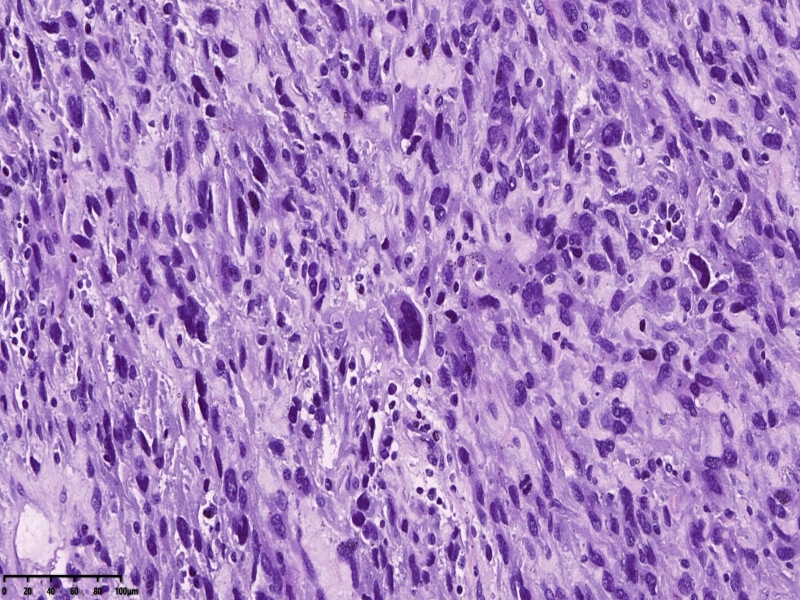

我的博文
子宫平滑肌肉瘤?
2025-10-26 10:32
阅读(64)
评论(0)
分类:女性生殖系统
患者绝经3年后不规则出血3个月,发现子宫肌瘤伴尿频入院254838
送检全子宫,宫体已被临床切开,内膜光滑,厚约0.1厘米,肌壁厚约2厘米,肌间可见肿物,已被临床切开,直径约8厘米,切面灰白灰黄。诊断软,局部质地脆。大体印象子宫平滑肌肉瘤待除外。
镜下可见肌间可见梭形瘤细胞,细胞核畸形,多核瘤巨细胞。坏死。

坏死?

免疫组化
SMA

Caldesm部分+

CD10部分+

CD10
ki67

cd34

ER 部分+

PR-
Desmin-
会诊结果:子宫体间叶组织来源的肿瘤,形态学符合恶性。依据免疫组化结果,可排除肌源性肿瘤、胃肠间质瘤、子宫内膜间质肿 瘤、神经源性肿瘤、孤立性纤维性肿瘤等。 考虑可能为纤维肉瘤。
本文允许在互联网范围内转载,使用时请注明作者姓名、作品名称及作品来源。
上一篇:乳腺叶状肿瘤
下一篇:食管-贲门-胃体肿物。
我要评论
共0条评论